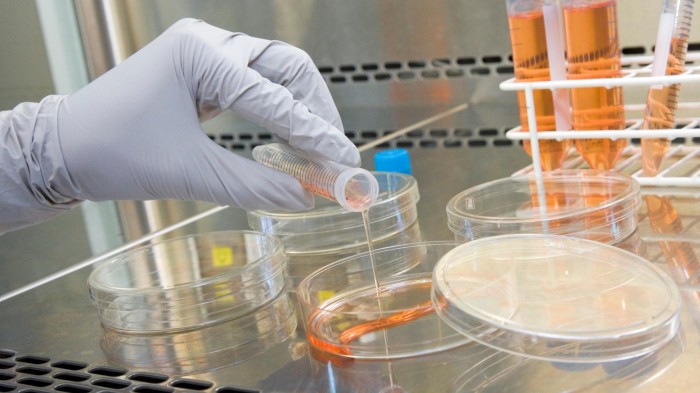
A close-up of a researcher pouring a liquid from a test tube into a petri dish

Sblocca gratuitamente il digest dell'editore
Lo stress finanziario che deve affrontare molte università del Regno Unito li sta spingendo a cercare nuove fonti di denaro. Ecco le cattive notizie per coloro che sperano che gli spinout della tecnologia e della ricerca di scienze della vita colpiscano il divario: non solo saranno delusi, ma potrebbero anche perdere un'opportunità a lungo termine.
Non pensare la mia parola, ma ascolta Anne Lane, che dirige UCL Business, l'operazione di trasferimento tecnologico dell'University College di Londra. L'UCL è nel “triangolo d'oro” delle università di ricerca che collega Londra, Oxford e Cambridge ed è tra i più riusciti a trarre profitto commercialmente dalle invenzioni scientifiche e sanitarie che si estendono dalla sua ricerca.
Lo scorso anno l'UCL ha contribuito con £ 6 milioni in aiuti regalo all'università e ha guadagnato altri £ 18 milioni di entrate da invenzioni come la tecnologia alla base di Roctavian, un trattamento di terapia genica per l'emophilia A. Attualmente ha 95 società di spinout attive e 24 terapeutiche avanzate basate sulla sua ricerca in studi clinici. Non è, in altre parole, un Dunce finanziario.
Ma questo è ancora modesto rispetto al reddito dell'UCL di £ 2,1 miliardi dell'anno scorso, o all'interno di ciò le sue sovvenzioni e contratti di ricerca di £ 538 milioni. “Gli accademici vogliono essere coinvolti perché dà il loro lavoro a impatto sul mondo reale. Se qualcuno sperava [fully] Ricerca finanziaria con gli spinout, sarebbe una lunga attesa “, afferma Lane.
O ascolta Lord Jim O'Neill, presidente di Northern Gritstone, il fondo di investimento partner di £ 312 milioni di università di Leeds, Manchester e Sheffield. Le università “devono apprezzare quanto sia rischioso gli investimenti di impresa e non sperano in un flusso di reddito garantito … se cercano di dominare l'equità e controllare tutta la proprietà intellettuale, non saranno in grado di attrarre investitori”.
La buona notizia è che, nonostante le sfide finanziarie che devono affrontare le università e il fatto che molti stanno arrivando in ritardo all'opportunità di commercializzazione della ricerca, esiste. Una volta che alcune scommesse sulle tecnologie si trasformano in un ecosistema in cui i ricercatori di un'università possono trasformare facilmente e coerentemente le idee in iniziative, inizia a diventare radicate.
Più modeste sono le aspettative a breve termine di un'università e più agile è girare o in licenza la sua proprietà intellettuale, più è guadagnare alla fine. “È meglio solo prendere un po 'di tutto che cercare di giocare a Venture Capital”, afferma David Grimm, partner di AlbionVC, che ha collaborato con UCL su due fondi di investimento spinout.
Le università lo stanno riconoscendo, incoraggiata da una revisione del 2023 di spinout co-guidata da Irene Tracey, vice-cancelliere dell'Università di Oxford. Un recente studio del gruppo di ricerca Beauhurst ha scoperto che le quote azionarie delle università negli spinout sono scese a un minimo di 10 anni del 16 %. Ciò apre più equità a inventori e investitori.
Assumere meno equità e adottare un modello standard piuttosto che negoziare individualmente e lentamente su ogni potenziale invenzione porta due benefici. Uno è che promuove una scala maggiore, in particolare a fianco di fondi di investimento partner. Il secondo è che dà a un'università un ruolo economico tangibile e attira i ricercatori che preferiscono combinare ricerche pure e applicate.
Una dimensione non si adatta a tutta la gamma di ricerche scientifiche e tecnologiche in istituzioni come l'UCL. Per il software e l'intelligenza artificiale, gli imprenditori devono essere sviluppati dagli imprenditori per avere un vero valore finanziario. Per le scienze della vita, le molecole e le terapie che emergono dai laboratori universitari possono avere un valore brevettabile e duraturo.
Pertanto, l'UCLB adotta un approccio abbastanza aperto agli spinout del software, incoraggiando chiunque abbia un'idea aziendale a svilupparlo e in licenza il diritto al 5 % del patrimonio netto. Per i medicinali, tende a conservare in gioco più grandi o lavorare con gli accademici per autorizzare la proprietà intellettuale alle società di biotecnologia, il che è meno rischioso e offre un flusso di entrate dai royalties.
Il fatto che UCL abbia un ufficio di trasferimento tecnologico praticato aiuta. Il think-tank in seguito l'anno scorso ha criticato gli uffici di molte università come privo di finanziamenti, capacità e competenza. Più grande è l'operazione universitaria, più è probabile che funzioni bene con gli investitori e traggano finanziamenti per il concetto di potenziali spin-off.
Quindi ci sono molte ragioni per cui le università possono prendere sul serio gli spin-off e consentire fondi partner come Northern Gritstone. Dimentica di cercare di riempire un buco nel budget e concentrati sul rendere le università più coinvolte e inventive. Pagherà in tempo.